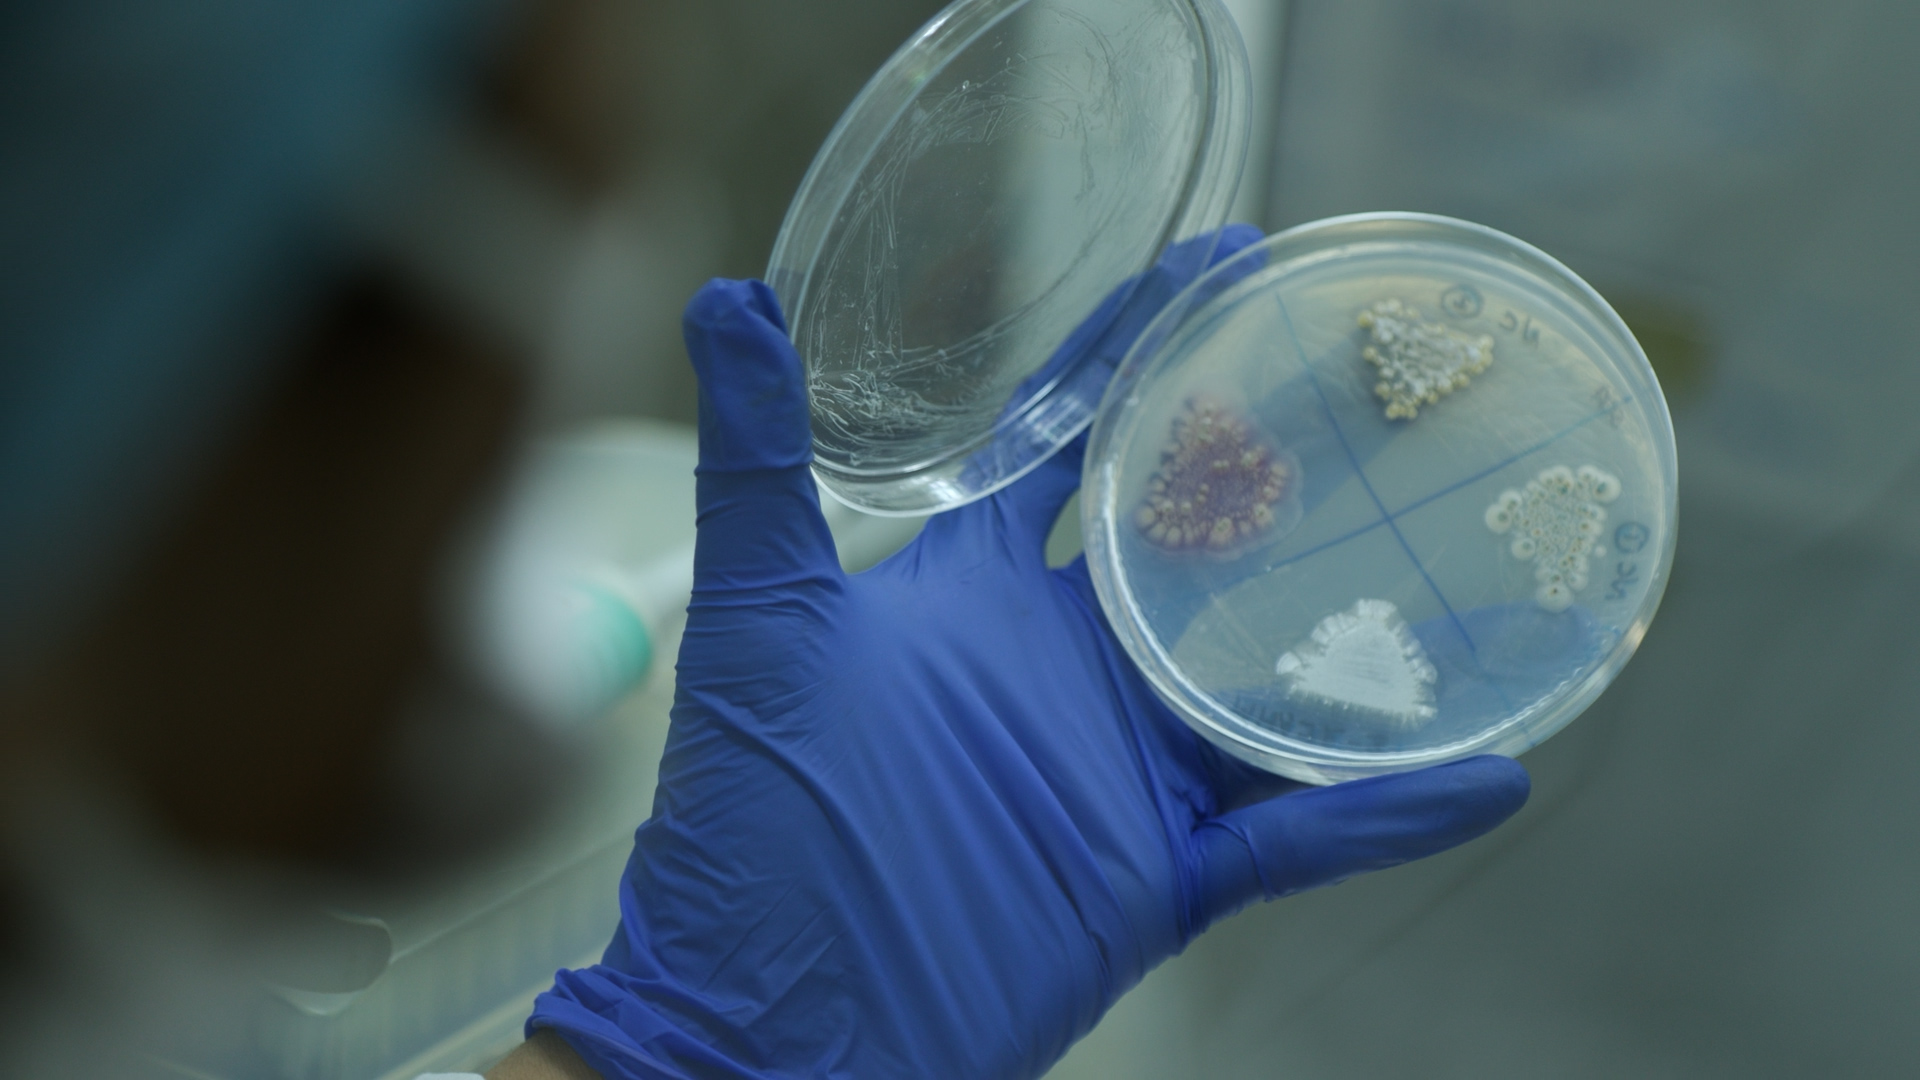

India stands at a turning point for agrifoodtech investment.
With $2.5 billion of agrifoodtech funding in 2024, the country holds an undisputed lead in the developing world, thanks in no small part to the plethora of smallholder-farmer-focused ag marketplaces and quick-delivery heavyweights such as Swiggy and Zepto.
But as these sectors mature and consolidate, the need to channel more VC dollars into life sciences is becoming more apparent.
The latter category in India is a grossly underinvested one. Despite a billion-strong population, growing economy, and ample pool of talent, India’s progress in fields such as ag biotech, alternative materials and ingredients, and biopharma (to name just a few) lags far behind other leading markets like the United States, as well as China.
“India is becoming a global outlier, with the USA, Israel, Europe, and China all building unicorn startups in agrifood life sciences,” Mark Kahn, managing partner of impact VC firm Omnivore, wrote in 2021.
Four years later, Omnivore has launched a new initiative to address this lackluster entrepreneurial activity and bring more VC investment into India’s life sciences called Biowave.
Founded by Omnivore, student-led biotech education hub Nucleate, and early-stage investor IndieBio, and supported by Indian organizations BIRAC, C-CAMP, IKP, the Bangalore Bioinnovation Centre, Venture Center, and SINE (IIT Bombay), Biowave is building more opportunities for interaction between startups and investors.
In doing so, the initiative will boost awareness of life sciences in order to increase understanding about where the sector is at today and, more importantly, how to move it forward effectively.

‘Progress has been anemic’
The burden of climate change sits heavy on the shoulders of India—one need only look at pictures of the country’s droughts and devastating heatwaves in 2023 and 2024 to confirm this. Meanwhile, some climate experts say India will be one of the first places where temperatures cross the limits of survivability by 2050.
“Digital technologies alone are insufficient to ensure a future in rural India that’s not only liveable but thriving,” says Omnivore’s Mark Kahn.
Innovations in life sciences, he adds, must accelerate in order to meet the challenges in tackling both climate mitigation and adaptation.
And yet, as an investment category, this area is strikingly underfunded.
Startups across Indian agrifoodtech raised $2.5 billion in 2024, up 63% from the previous year, according to AgFunder’s Developing Markets AgriFoodTech Investment report produced in partnership with Omnivore, alongside Dutch development bank FMO and sugar reduction company BlueTree Technologies.

The majority of the funding went to downstream categories related to food delivery as well as midstream technologies and ag marketplaces.
The AgFunder-defined Ag Biotech category, which falls under the umbrella of life sciences, raised just $12 million across 12 deals in 2024—or 6% of that $3.7 billion total figure.

In contrast, US-based Ag Biotech startups raised nearly $1 billion in 2024; in China, they raised $418 million.
“India’s story is very different from the rest of the world,” says Saborni Poddar, VP of special projects at Omnivore. “Somehow, the progress has been very anemic.”
As she tells it, there is not enough funding currently going into the life sciences space in India. At the same time, there is “a dearth” of investors who actually understand this area.
“That very symbiotic intersection where people from life sciences are entering into the VC space, marrying private equity capital with startups worth betting on, has not really happened,” she says.
“The whole idea behind Biowave is to make people aware that there is money we need, and that investors need to support; if they want to come into this space, they need to support entrepreneurs earlier and earlier in the journey,” she adds.
Education a ‘critical component’
The Biowave initiative facilitates connections among investors, entrepreneurs, researchers, and others via events and meetups.
It recently held its first meetup, an invite-only conference that hosted a number of scientists, founders, and investors. In particular, the Biowave team invited “a very select number of venture capitalists who have exposure to the space, who can share their experience about what’s working, what’s not working,” says Poddar.
Education is a major component of the operation, as it’s critical to ensure that potential investors understand the slower timelines in life sciences versus, say, a quick-delivery app a la Zepto.
“Time is the biggest elephant in the room,” notes Poddar. “When investors come into the space, they need to understand that this is not going to be a quick, four-year journey and then they get an exit. The R&D phase for something like a Zepto or a Blinkit is very low compared to developing, say, biomaterial for advanced wound healing.”
With such a strong focus on education, Biowave hopes to avoid some of the problems agrifoodtech investment in developed countries has faced around this, as generalist investors wrote big checks then fled the space when returns failed to materialize quickly.
VC money in India still goes where the largest and easiest opportunities exist, notes Kahn.
Part of this is because most of them come from digital technology backgrounds, not life sciences.
Here there is an opportunity for the country’s universities and institutes (including CSIR and ICAR) to foster a greater spirit of entrepreneurship amongst researchers, graduate students and professors. As such, participation in Biowave’s events will be crucial for forging connections via the initiative.
“One great thing about the biosciences space in India is that the government has been very supportive,” says Poddar.
Four years ago, there was barely any VC money going to ag biosciences.
“The government at that time really stepped up. There were grants. There was a lot of non-dilutive capital that was available, and that really helped buoy the sector in the absence of any real private investments.”
Startups to watch
The top funding round for an Indian Ag Biotech startup in 2024 went to BioPrime, a company developing next-generation biologicals for crop resilience and soil health improvement.
The company raised a $6 million Series A round in the second half of the year, led by Belgium-based Edaphon, with participation from Omnivore and Inflexor Ventures.
“Recognizing the hyper-local nature of Indian agriculture, we’ve built robust, adaptive formulations and pioneered seed-to-harvest cohort programs in key crops to drive behavior change and boost productivity,” the company noted in AgFunder’s report.
It is currently focusing on product launches for its biofungicides, biostimulants, and fertilizer additives, with plans to enter the US and Southeast Asia markets in 2025.
Another top round went to Invati, which is currently addressing efficient energy storage for agrifood and animal health industries via biomanufacturing solutions.
The company raised a $5.4 million Series A round in 2024.
While there were only a handful of tiny raises in the space in 2024, Poddar remains optimistic about the growth of Ag Biotech and the life sciences space in general.
“Right now we are at a place where we can proudly say that we’re one of the best countries when it comes to agritech innovations specifically tailored to the Indian challenges like climate and small landholdings,” she notes.
“So maybe we are at the point where the same thing would probably happen over a period of time for life sciences.”
The post Investment in India’s life sciences crawls behind US and China. A new initiative could change that appeared first on AgFunderNews.

